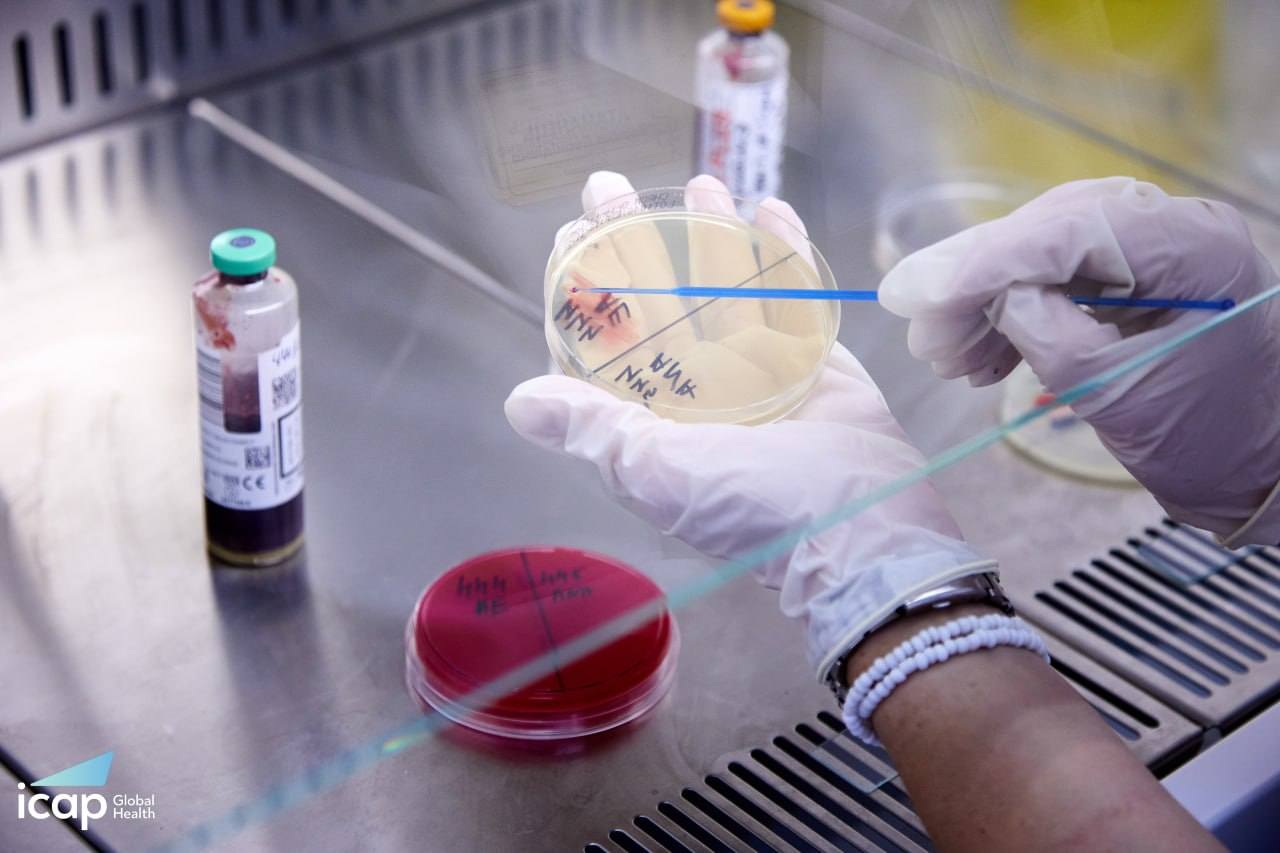
658221059_1505727348013029_3946986119836251988_n.jpg

До переліку акредитованих напрямків, окрім біохімічних і імунохімічних, додано бактеріологічний підрозділ, що гарантує міжнародний рівень діагностики для кожного пацієнта.
Підготовка до проходження акредитації тривала близько року.
За словами фахівців лабораторії, за цими високими стандартами вони працюють уже давно, однак тепер цей рівень офіційно підтверджено міжнародною комісією.
"Отримання цієї акредитації про компетентність – це про рівень довіри. Ми працюємо за тими стандартами, які є максимальними, і наша робота якісна та відповідає міжнародним вимогам", – зазначає лікар-бактеріолог Наталя Красій.
Отримання міжнародної акредитації має важливе значення для пацієнтів, адже точність лабораторних результатів є основою правильного діагнозу та ефективного лікування.
Особливо це важливо сьогодні, коли зростає кількість полірезистентних штамів бактерій.
"Ми можемо чітко підказати лікареві, які саме антибіотики будуть найбільш ефективними для пацієнта. Це надзвичайно важливо для лікування, навіть з економічної точки зору, адже такий пацієнт буде перебувати у стаціонарі коротший термін", – пояснює лікар-бактеріолог Олена Покришко.
Лабораторія обласної клінічної лікарні забезпечена сучасним обладнанням, що дозволяє проводити дослідження на високому професійному рівні.
У підготовці до акредитації нашим фахівцям допомагала міжнародна організація ICAP (США), якій вони висловлюють вдячність за підтримку та консультативну допомогу.
Варто зазначити, що у Тернопільській області це перша клінічна лабораторія, яка отримала такий сертифікат.
А це не лише професійне досягнення колективу, а є також важливим кроком для розвитку лабораторної діагностики в регіоні та підвищення якості медичної допомоги для пацієнтів.